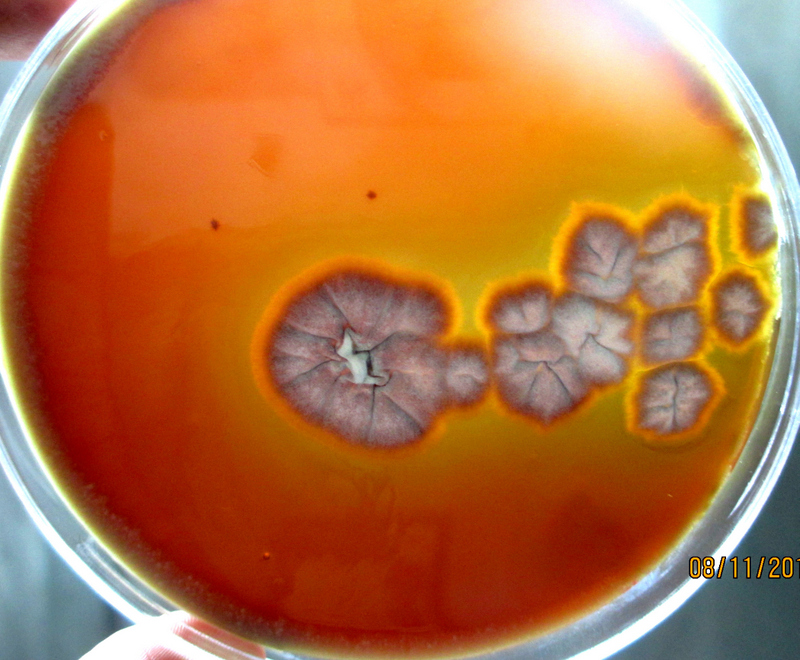

Enzymatic and Non-Enzymatic Virulence Activities of Dermatophytes on Solid Media
Elangovan Elavarashi1, Anupma Jyoti Kindo2, Sudha Rangarajan3
1 Lecturer, Department of Biotechnology, Sri Ramachandra University, Chennai, Tamil Nadu, India.
2 Professor, Department of Microbiology, Sri Ramachandra University, Chennai, Tamil Nadu, India.
3 Professor, Department of Dermatology, Venereology and Leprosy, Sri Ramachandra University, Chennai, Tamil Nadu, India.
NAME, ADDRESS, E-MAIL ID OF THE CORRESPONDING AUTHOR: Dr. Anupma Jyoti Kindo, Department of Microbiology, Sri Ramachandra University, Porur, Chennai - 600116, Tamil Nadu, India.
E-mail: anupmalakra@gmail.com
Introduction
Dermatophytes are keratinophilic fungi causing superficial cutaneous infections that account 20-25% of the global population. As per literature search, there is a dearth in the study on virulence factors of dermatophytes from the Indian sub-continent and moreover the association of the virulence factors and the host tissue in vitro helps in understanding the host-pathogen interaction.
Aim
To analyse the enzymatic and non-enzymatic virulence activities of dermatophytes on solid media.
Materials and Methods
A total of 11 isolates, three standard American Type Culture Collection (ATCC) strains- Trichophyton rubrum- 28188, Trichophyton mentagrophytes- 9533, Trichophyton tonsurans- 28942, one CBS KNAW Fungal Biodiversity Centre strain- Arthroderma grubyi- 243.66, five clinical isolates- T. rubrum, T. mentagrophytes, Trichophyton rubrum var. raubitschekii, Trichophyton interdigitale, Epidermophyton floccosum, and two laboratory isolates - Microsporum gypseum and Microsporum canis were screened for the production of virulence enzymes such as phospholipase, lipase, protease, gelatinase and non-enzyme virulence factors (haemolytic activity) of dermatophytes. The clinical isolates were identified from a tertiary care hospital, Chennai. These dermatophytes were tested upon specific substrates on solid media such as egg yolk, tween 80, bovine serum albumin, gelatin powder and sheep blood respectively.
Results
The virulence activity of phospholipase, lipase, protease and gelatinase was observed from all the dermatophyte species. T. rubrum, T. rubrum ATCC strain, T. rubrum var. raubitschekii, T. mentagrophytes, T. mentagrophytes ATCC strain, T. interdigitale and A. grubyi CBS strain produced complete haemolysis, whereas other dermatophytes showed no haemolytic activity.
Conclusion
Phospholipase, lipase, protease and gelatinase act as enzymatic virulence marker and the T. rubrum complex, T. mentagrophytes complex and A. grubyi showed complete haemolysis and hence they may also act as a non-enzymatic virulence marker for dermatophytes.
Gelatinase, Hamolysis, Lipase, Phospholipase, Protease
Introduction
Dermatophytosis is a superficial fungal infection caused by dermatophytes of the anamorphic genera– Trichophyton, Microsporum and Epidermophyton. Dermatophytes are keratinophilic fungi, infecting the skin, hair and nails of humans and animals. Dermatophyte infections are usually restricted to the outer layer of the epidermis and unable to penetrate the deeper tissues of a healthy individual [1]. Dermatophytes are grouped according to their natural habitat as anthropophiles (human associated), zoophiles (animal associated) and geophiles (soil dwelling). Dermatophytes produce a variety of virulence enzymes such as keratinase, protease, phospholipase, lipase and elastase upon different substrate specificities, which are involved in the pathogenicity of host tissues [2]. Adherence of infectious material from dermatophytes to the keratinized host tissue is the first initiation step in dermatophyte infection. The infection is usually transmitted through direct contact with the infected humans or animals or by indirect contact with the contaminated fomites. After adherence, the spores germinate and penetrate to the stratum corneum cells for the strong attachment sites and nutrients, during which the dermatophytes produces a variety of virulence factors which includes both enzymes and non-enzymes [2].
The keratinase is produced by bacteria (Bacillus species) [3,4] Streptomyces [5] and fungi (dermatophytes) [6]. Dermatophytes are known to colonize the outer layer of the epidermis, which is rich in keratinous material such as skin, hair and nails. Besides keratinase, protease is one of the major virulence enzymes secreted by dermatophytes [2]. The protease is produced when the dermatophytes are cultured in a medium enriched with protein substrate as a sole nitrogen source. The phospholipase activity of dermatophytes is observed upon hydrolysis of phospholipids into fatty acids and lipophilic substances. Therefore, keratinase, protease and phospholipase are the major virulence enzymes produced during infection [2].
Among the non-enzymatic virulence factors, T. rubrum produces a mycotoxin called xanthomegnin, which is known to be produced by food-borne Penicillium and Aspergillusin vitro and in vivo causing nephropathy and death in animals. The xanthomegnin is the major substance that gives red pigmentation on reverse of the T. rubrum culture and it was observed in infected skin and nail specimens. The xanthomegnin level is varied among the clinical samples [7]. Few dermatophyte species produce melanin or melanin like compounds in vitro and in vivo and play similar role in the pathogenesis of other dermatophytic diseases [8]. There is a dearth in the study on virulence factors from the Indian subcontinent and moreover, the association of the virulence factors and the host tissue in vitro helps in understanding the host-pathogen interaction. Therefore in the present study, an attempt was made to analyse the virulence enzymes such as protease, phospholipase, lipase, gelatinase and non-enzyme virulence activities (haemolysis) of dermatophyte species.
Materials and Methods
Retrospective analysis of the virulence activity was conducted from January 2013 to December 2013, in a tertiary care centre, Chennai. A total of 11 isolates, three standard American Type Culture Collection (ATCC) strains- Trichophyton rubrum- 28188, Trichophyton mentagrophytes- 9533, Trichophyton tonsurans- 28942, one CBS strain - Arthroderma grubyi - 243.66, five clinical isolates- T. rubrum, T. mentagrophytes, Trichophyton rubrum var. raubitschekii, Trichophyton interdigitale, Epidermophyton floccosum, and two laboratory isolates - Microsporum gypseum and Microsporum canis previously isolated from skin scrapings were screened for the virulence activities of dermatophytes on solid media. The analysis of virulence activity of dermatophyte species was done in duplicates. Ethical approval was obtained from the institutional review board for conducting the study (IEC-NI/09/DEC/13/40).
Production of Phospholipase
The phospholipase assay was performed according to the method described in earlier study [9]. The phospholipase medium contained peptone 1%, dextrose 2%, sodium chloride 5.73%, calcium chloride 0.05% and agar 2%. The medium was autoclaved and allowed to cool at 50°C. The egg yolk was separated and poured to a sterile flask containing glass beads. The egg yolk was completely mixed by vigorous shaking. A 5% egg yolk was added to the molten Sabouraud Dextrose Agar (SDA) at approximately 50°C. The spore suspension was inoculated and incubated at 37°C. Candida albicans was used as positive control. A clear halo zone of clearance around the colony indicated phospholipase production.
Production of Lipase
The lipase assay was performed as described in previous study [9]. The lipase medium contained peptone 1%, sodium chloride 5%, calcium chloride 0.01% and agar 2%. The medium was autoclaved and 1% tween 80 was added to the molten medium at approximately 50°C. The enriched medium was mixed thoroughly and poured in sterile petridish. The spore suspension was inoculated and incubated at 37°C. Malassezia furfur was used as positive control. A clear halo zone of precipitation around the colony indicated lipase production.
Production of Protease
The protease assay was performed by modified plate method [10]. The medium contained dextrose 2%, potassium dihydrogen phosphate 0.1%, magnesium phosphate 0.05% and agar 2%. The medium was allowed to cool and 1% bovine serum albumin was added to the molten medium at approximately 50°C. The enriched medium was mixed thoroughly and poured in sterile petridish. The spore suspension was inoculated and incubated at 37°C. Candida albicans was used as positive control. A clear halo zone of clearance around the colony indicated protease production.
Production of Gelatinase
Nutrient gelatin stab method was performed for the detection of gelatin hydrolysis. The nutrient gelatin medium contained peptone special (5 g/L), beef extract (3 g/L) and gelatin (120 g/L) and autoclaved. A total volume of 5 ml was added in each test tube and allowed to cool in an upright position. The test organisms were stab inoculated into gelatin tubes and the un-inoculated tubes were incubated at 25°C for a week and reviewed for gelatin liquefaction at regular intervals. Staphylococcus aureus was used as positive control. Gelatin usually liquefies at 28°C and above and therefore to confirm gelatin liquefaction due to gelatinase production, the test and the un-inoculated gelatin tubes were refrigerated at 4°C for 30 minutes. Later, the tubes were tilted to observe for gelatin liquefaction. The hydrolyzed gelatin resulted in liquid state even after exposure to cold temperature demonstrated gelatinase production, whereas the un-inoculated tubes remained in solid state.
Detection of Haemolytic Activity
Columbia blood agar base supplemented with sheep blood was utilized for the detection of haemolytic activity [11]. The sheep blood (5%) was added to the molten blood agar base at approximately 50°C. The medium was mixed properly and poured in sterile petridish. A small cup was made at the center of the blood agar plate and the spore suspension was inoculated and incubated at 37°C. Streptococcus pyogenes was used as positive control. A transparent zone of clearing around the colony indicated complete haemolysis.
Results
The virulence activity of phospholipase [Table/Fig-1], lipase [Table/Fig-2], protease [Table/Fig-3] and gelatinase [Table/Fig-4] was observed from all the dermatophyte species. T. rubrum complex, T. mentagrophytes complex showed very strong positive results for phospholipase, lipase and protease activity, whereas others showed positive activity. All dermatophyte species tested showed very strong positive results for gelatinase activity. T. rubrum, T. rubrum ATCC strain, T. rubrum var. raubitschekii, T. mentagrophytes, T. mentagrophytes ATCC strain, T. interdigitale and A. grubyi CBS strain produced complete haemolysis [Table/Fig-5]. Other dermatophyte species such as T. tonsurans, E. floccosum, M. gypseum and M. canis showed no haemolytic activity.
Phospholipase activity on egg yolk medium – a clear halo zone of clearance around the colony indicated phospholipase production;

Lipase activity on tween 80 medium- a clear halo zone of precipitation around the colony indicated lipase production.

Protease activity on Bovine Serum Albumin (BSA) medium- a clear halo zone of clearance around the colony indicated protease production;

Gelatinase activity on nutrient gelatin medium- The hydrolyzed gelatin resulted in liquid state even after exposure to cold temperature demonstrated gelatinase production, whereas the un-inoculated tubes remained in solid state.

Haemolytic activity on Columbia blood agar base with sheep blood- a transparent zone of clearing around the colony indicated complete haemolysis.
Discussion
The virulence activities of dermatophytes such as phospholipase, lipase, protease, gelatinase and haemolytic activity were analysed on solid media. The phospholipase hydrolyzes phospholipids into fatty acids and other lipophilic substances. Likewise the lipase hydrolyzes lipids. The protease has proteolytic activity wherein it breaks down the proteins into polypeptides and amino acids. The gelatinase hydrolyze gelatin into sub-components such as polypeptides, peptides and amino acids. Based on the literature search, the gelatinase activity of dermatophyte species was analysed for the first time in India. The medium enriched with specific substrates showed rapid growth of dermatophytes within 3-5 days of incubation showing that they have the ability to breakdown the substrate present in the skin of patients with dermatophytosis for their growth. The virulence enzymes were produced by all the dermatophyte species which was similar to the earlier virulence study [12] and hence acts as virulence marker for dermatophytes.
The dermatophytes initially break the lipid surface layer during the first phase of growth and subsequently, colonize the stratum corneum of the skin [13]. Hence, lipase enzyme plays a vital role during dermatophytic infections. A variety of analytical methods were employed for the determination of lipase activity such as volumetry, spectrometry, radioactive assay, immunoassays, conductimetry, chromatography and biosensors [14]. These emerging techniques can be developed for the quantification of lipolytic activity of dermatophyte species. Hellgren L and Vincent L reported that the lipolytic activity was found to be high in old cultures of E. floccosum [13]. The proteolytic activity of T. rubrum isolates was varied based on the following parameters such as pH, temperature, incubation period and substrate concentration. The proteolytic activity plays a major role in the penetration and pathogenesis during dermatophytic infection [15].
The dermatophytes usually colonize the epidermal layer of the skin and they are unable to penetrate the deeper tissues of an immunocompetent individual [1]. The immunological response of the host to the metabolic products released by the fungus is directly proportional to the severity of the infection, which may result from mild to acute inflammation [1]. The humoral and cellular immunity involves activation of the lymphocytes, macrophages, neutrophils and mast cells at the site of infection. The haemolysins are the lipids and proteins which are toxic to these cells in many bacterial infections. Likewise, the haemolysins produced by dermatophytes may also act similarly and decline the immune response of the host [11]. The Columbia blood agar base with sheep blood showed slow growth for about 20 days of incubation at 37°C and observed single complete zone of haemolysis on T. rubrum complex, T. mentagrophytes complex and A. grubyi. This non-enzyme virulence activity with a variety of dermatophyte species was analysed for the first time in India.
Schaufuss P and Steller U reported bizonal haemolytic activity of T. rubrum and T. equinum where a complete zone of haemolysis was surrounded by a small incomplete zone demonstrating that two different cytolytic activities were expressed, whereas T. mentagrophytes and T. verrucosum produced single complete zone of haemolysis observed around the colony [11].
There is a dearth in the study on virulence enzymes and moreover there were no database to compare the molecular study on virulence enzymes of dermatophytes. Recently, the completed dermatophyte genome sequences are made available to the public, to utilize the opportunity using Bioinformatics tool to identify the virulence genes responsible for their activity and analyse the key components of the dermatophyte species to adapt the selective ecological groups [16].
Conclusion
The phospholipase, lipase, protease and gelatinase act as enzymatic virulence marker and the T. rubrum complex, T. mentagrophytes complex and A. grubyi showed complete haemolysis and hence, they may also act as a non-enzymatic virulence marker for dermatophytes.
[1]. Weitzman I, Summerbell RC, The dermatophytesClin Microbiol Rev 1995 8:240-59. [Google Scholar]
[2]. Chinnapun D, Virulence factors involved in pathogenicity of dermatophytesWalailak J Sci & Tech 2015 12:573-80. [Google Scholar]
[3]. Lakshmi PJ, Chitturi MK, Lakshmi VV, Efficient biodegradation of feather by keratinase producing Bacillus spInt J Microbiol 2013 2013:608321 [Google Scholar]
[4]. Kainoor PS, Naik GR, Production and characterization of feather degrading keratinase from Bacillus sp. JB 99Indian J Biotechnol 2010 9:384-90. [Google Scholar]
[5]. Syed DG, Lee JC, Li WJ, Kim CJ, Agasar D, Production, characterization and application of keratinase from Streptomyces gulbargensisBioresour Technol 2009 100:1868-71. [Google Scholar]
[6]. Sharma A, Chandra S, Sharma M, Difference in keratinase activity of dermatophytes at different environmental conditions is an attribute of adaptation to parasitismMycoses 2012 55:410-15. [Google Scholar]
[7]. Gupta AK, Ahmad I, Borst I, Summerbell RC, Detection of xanthomegnin in epidermal materials infected with Trichophyton rubrumJ Invest Dermatol 2000 115:901-05. [Google Scholar]
[8]. Youngchim S, Pornsuwan S, Nosanchuk JD, Dankai W, Vanittanakom N, Melanogenesis in dermatophyte species in vitro and during infectionMicrobiology 2011 157:2348-56. [Google Scholar]
[9]. Price MF, Wilkinson ID, Gentry LO, Plate method for detection of phospholipase activity in Candida albicansSabouraudia 1982 20:7-14. [Google Scholar]
[10]. Vijayaraghavan P, Vincent SGP, A simple method for the detection of protease activity on agar plates using bromocresol green dyeJ Biochem Tech 2013 4:628-30. [Google Scholar]
[11]. Schaufuss P, Steller U, Haemolytic activities of Trichophyton speciesMed Mycol 2003 41:511-16. [Google Scholar]
[12]. Muhsin TM, Aubaid AH, al-Duboon AH, Extracellular enzyme activities of dermatophytes and yeast isolates on solid mediaMycoses 1997 40:465-69. [Google Scholar]
[13]. Hellgren L, Vincent L, Lipolytic activity of some dermatophytesJ Med Microbiol 1980 13:155-57. [Google Scholar]
[14]. Stoytcheva M, Montero G, Zlatev R, León JA, Gochev V, Analytical methods for lipases activity determination: A reviewCurr Anal Chem 2012 8:400-07. [Google Scholar]
[15]. Kadhim SK, Al-Janabi JK, Al-Hamadani AH, In vitro, determination of optimal conditions of growth and proteolytic activity of clinical isolates of TrichophytonrubrumJ Contemp Med Sci 2015 1:9-19. [Google Scholar]
[16]. Achterman RR, White TC, Dermatophyte virulence factors: Identifying and analysing genes that may contribute to chronic or acute skin infectionsInt J Microbiol 2012 2012:358305 [Google Scholar]